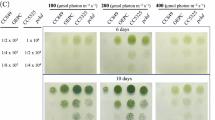

Abstract
Photosynthetic electron carriers are important in converting light energy into chemical energy in green plants. Although protein components in the electron transport chain are largely conserved among plants, algae and prokaryotes, there is thought to be a major difference concerning a soluble protein in the thylakoid lumen. In cyanobacteria and eukaryotic algae, both plastocyanin and cytochrome c6 mediate electron transfer from cytochrome b6f complex to photosystem I1,2,3,4. In contrast, only plastocyanin has been found to play the same role in higher plants. It is widely accepted that cytochrome c6 has been evolutionarily eliminated from higher-plant chloroplasts5,6. Here we report characterization of a cytochrome c6-like protein from Arabidopsis (referred to as Atc6). Atc6 is a functional cytochrome c localized in the thylakoid lumen. Electron transport reconstruction assay showed that Atc6 replaced plastocyanin in the photosynthetic electron transport process. Genetic analysis demonstrated that neither plastocyanin nor Atc6 was absolutely essential for Arabidopsis growth and development. However, plants lacking both plastocyanin and Atc6 did not survive.
This is a preview of subscription content, access via your institution
Access options
Subscribe to this journal
Receive 51 print issues and online access
$199.00 per year
only $3.90 per issue
Buy this article
- Purchase on SpringerLink
- Instant access to the full article PDF.
USD 39.95
Prices may be subject to local taxes which are calculated during checkout




Similar content being viewed by others
References
Crofts, A. R. & Wood, P. M. Photosynthetic electron transport chains if plants and bacteria and their role as proton pumps. Curr. Top. Bioenerg. 7, 175–244 (1978)
Hauska, G. A., McCarty, R. E., Berzborn, R. J., Racker, E. . J. Biol. Chem. 246, 3524–3531 (1971)
Malkin, R. & Niyogi, K. in Plant Biochemistry and Molecular Biology (eds Buchanan, B. B., Gruissem, W. & Jones, R. L.) 568–629 (American Society of Plant Physiologists, Rockville, Maryland, 2000)
Merchant, S. in Metal Ions in Gene Regulation (eds Silver, S. & Walden, W.) 450–467 (Chapman and Hall, New York, 1998)
De la Cerda, B., Diaz-Quintana, A., Navarro, J. A., Hervas, M. & De la Rosa, M. A. Site-directed mutagenesis of cytochrome c6 from Synechocystis sp. PCC6803: The heme protein possesses a negatively charged area that may be isofunctional with the acidic patch of plastocyanin. J. Biol. Chem. 274, 13292–13297 (1999)
Hippler, M., Drepper, F., Rochaix, J.-D. & Muehlenhoff, U. Insertion of the N-terminal part of PsaF from Chlamydomonas reinhardtii into photosystem I from Synechococcus elongatus enables efficient binding of algal plastocyanin and cytochrome c6. J. Biol. Chem. 274, 4180–4188 (1999)
Katoh, S. Studies on the algal cytochromes of C-type. Biochem. J. 46, 629–632 (1959)
Sigfridsson, K. Plastocyanin, an electron-transfer protein. Photosynth. Res. 57, 1–28 (1998)
Tobin, E. M. & Silverthorne, J. Light regulation of gene expression in higher plants. Annu. Rev. Plant Physiol. 36, 569–594 (1985)
Williams, J. G. Construction of specific mutations in photosystem II photosynthetic reaction center by genetic engineering methods in Synechocystis 6803. Methods Enzymol. 167, 766–778 (1988)
Atta-Asafo-Adjei, E. & Dilley, R. A. Plastocyanin stimulation of whole chain and photosystem I electron transport in inside-out thylakoid vesicles. Arch. Biochem. Biophys. 243, 660–667 (1985)
Wood, P. M. Interchangeable copper and iron proteins in algal photosynthesis. Studies on plastocyanin and cytochrome c-552 in Chlamydomonas. Eur. J. Biochem. 87, 9–19 (1978)
Waterhouse, P. M., Graham, M. W. & Wang, M. B. Virus resistance and gene silencing in plants can be induced by simultaneous expression of sense and antisense RNA. Proc. Natl Acad. Sci. USA 95, 13959–13964 (1998)
Chuang, C.-F. & Meyerowitz, E. M. Specific and heritable genetic interference by double-stranded RNA in Arabidopsis thaliana. Proc. Natl Acad. Sci. USA 97, 4985–4990 (2000)
Luan, S. & Bogorad, L. A rice gene promoter contains separate cis-acting elements for the expression in dicot and monocot plants. Plant Cell 4, 971–981 (1992)
Kim, J., Harter, K. & Theologis, A. Protein-protein interactions among the AUX/IAA proteins. Proc. Natl Acad. Sci. USA 94, 11786–11791 (1997)
Durfee, T. et al. The retinoblastoma protein associates with the protein phosphatase type-1 catalytic subunit. Genes Dev. 7, 555–569 (1993)
Gupta, R., Huang, Y., Kieber, J. J. & Luan, S. Identification of a dual-specificity protein phosphatase that inactivates MAP kinase from Arabidopsis. Plant J. 16, 581–590 (1998)
Krysan, P. J., Young, J. C. & Sussman, M. R. T-DN A as an insertional mutagen in Arabidopsis. Plant Cell 11, 2283–2290 (1999)
Ni, M., Cui, D., Einstein, J., Narasimhulu, S., Vergara, C. E. & Gelvin, S. B. Strength and tissue specificity of chimeric promoters derived from the octopine and mannopine synthase genes. Plant J. 7, 661–676 (1995)
Clough, S. J. & Bent, A. F. Floral dip: A simplified method for Agrobacterium-mediated transformation of Arabidopsis thaliana. Plant J. 16, 735–743 (1998)
Lin, Y., Wang, Y., Zhu, J.-K. & Yang, Z. Localization of a Rho GTPase implies a role in tip growth and movement of the generative cell in pollen tubes. Plant Cell 8, 293–303 (1996)
Somerville, C. R., Somerville, S. C. & Ogren, W. L. Isolation of photosynthetically active protoplasts and chloroplasts from Arabidopsis thaliana. Plant Sci. Lett. 21, 89–96 (1982)
Rippka, R., Deruelles, J., Waterbury, J., Herdman, M. & Stanier, R. Generic assignments, strain histories and properties of pure cultures of cyanobacteria. J. Gen. Microbiol. 111, 1–61 (1979)
Hervas, M. et al. Synechocystis-6803 plastocyanin isolated from both the cyanobacterium and E. Coli transformed cells are identical. FEBS Lett. 319, 257–260 (1993)
Zhang, L., McSpadden, B., Pakrasi, H. & Whitmarsh, J. Copper-mediated regulation of cytochrome-c553 and plastocyanin in the cyanobacterium Synechocystis-6803. J. Biol. Chem. 267, 19054–19059 (1992)
Quinn, J. M. & Merchant, S. Copper-responsive gene expression during adaptation to copper deficiency. Methods Enzymol. 297, 263–279 (1998)
Acknowledgements
We thank R. Malkin, J. Gray and S. Merchant for discussions. This work was supported by the National Institutes of Health and the US Department of Energy (S.L.).
Author information
Authors and Affiliations
Corresponding author
Ethics declarations
Competing interests
The authors declare that they have no competing financial interests.
Rights and permissions
About this article
Cite this article
Gupta, R., He, Z. & Luan, S. Functional relationship of cytochrome c6 and plastocyanin in Arabidopsis . Nature 417, 567–571 (2002). https://doi.org/10.1038/417567a
Received:
Accepted:
Issue date:
DOI: https://doi.org/10.1038/417567a
This article is cited by
-
Exploring Regulatory Roles of Plant Thylakoid-Bound Proteins Involved in Abiotic Stress Responses
Journal of Plant Growth Regulation (2024)
-
In vitro kinetics of P700 + reduction of Thermosynechococcus elongatus trimeric Photosystem I complexes by recombinant cytochrome c 6 using a Joliot-type LED spectrophotometer
Photosynthesis Research (2017)
-
Photosynthetic fuel for heterologous enzymes: the role of electron carrier proteins
Photosynthesis Research (2017)
-
Derek Bendall (1930–2014)
Photosynthesis Research (2015)
-
The effects of copper on the photosynthetic response of Phaeocystis cordata
Photosynthesis Research (2011)